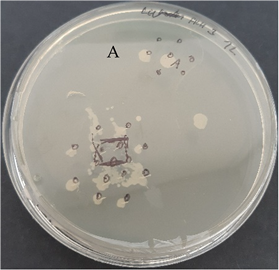
Nanomaterials 13 00844 i002

Abstract
Acne vulgaris is a prevalent skin condition that is caused by an imbalance in skin microbiomes mainly by the overgrowth of strains such as Cutibacterium acnes and Staphylococcus epidermidis which affect both teenagers and adults. Drug resistance, dosing, mood alteration, and other issues hinder traditional therapy. This study aimed to create a novel dissolvable nanofiber patch containing essential oils (EOs) from Lavandula angustifolia and Mentha piperita for acne vulgaris treatment. The EOs were characterized based on antioxidant activity and chemical composition using HPLC and GC/MS analysis. The antimicrobial activity against C. acnes and S. epidermidis was observed by the determination of the minimum inhibitory concentration (MIC) and minimum bactericidal concentration (MBC). The MICs were in the range of 5.7–9.4 μL/mL, and MBCs 9.4–25.0 μL/mL. The EOs were integrated into gelatin nanofibers by electrospinning and SEM images of the fibers were taken. Only the addition of 20% of pure essential oil led to minor diameter and morphology alteration. The agar diffusion tests were performed. Pure and diluted Eos in almond oil exhibited a strong antibacterial effect on C. acnes and S. epidermidis. After incorporation into nanofibers, we were able to focus the antimicrobial effect only on the spot of application with no effect on the surrounding microorganisms. Lastly, for cytotoxicity evaluation, and MTT assay was performed with promising results that samples in the tested range had a low impact on HaCaT cell line viability. In conclusion, our gelatin nanofibers containing EOs are suitable for further investigation as prospective antimicrobial patches for acne vulgaris local treatment.
1. Introduction
The skin is the body’s largest organ (approx. 1.8 m2). It possesses numerous functions from barrier function, heat regulation, protection of organs from the harmful surrounding environment, etc. The skin is naturally inhabited by numerous microorganisms referred to as skin microbiome [1,2]. The estimated density of these microbial communities is 1 million bacteria/cm2. The representation of individual species varies from the individual body part. At the genus level, Curibacterium (Propionibacterium) and Staphylococcus are commonly identified together with Corynebacterium [1].
Disbalance of the skin microbiome can easily lead to skin diseases one of the most common is acne vulgaris [3], affecting over 80% of adolescents [4] and approximately 50% of adults older than 25 years. In this older acne group, we can distinguish two separate populations of patients. The first one developed acne during adolescence and have persistent acne and the second group developed de novo acne during adulthood [5]. Acne is manifested by comedones, papules, pustules, and cysts. In the onset of acne, not only one, but several factors apply to its development [6].
In recent years, not only C. acnes but other bacteria are studied concerning acne vulgaris. The microbiology of the pilosebaceous unit involves three coexisting groups of microorganisms: gram-positive, coagulase-negative cocci (staphylococci and micrococci); anaerobic diphtheroids (Cutibacterium acnes and Cutibacterium granulosum), and lipophilic yeasts (Pityrosporumspecies). The microflora of comedones is qualitatively identical to that of the normal sebaceous follicle [6]. Other commonly found species in pilosebaceous units included Staphylococcus epidermidis, Cutibacterium humerusii, and Cutibacterium granulosum, each representing 1–2.3% of the total clones [7].
Acne pathogenesis is a multi-factor disease, as both skin microbiota and inflammation play a role in it. The pathophysiology of acne involves abnormal follicular hyperkeratinization, excessive sebum production, colonization by C. acnes [8], and subsequent activation of an inflammatory cascade [9]. Moreover, acne demonstration can induce lower self-attitude and self-worth not only in teenagers but adults as well [10].
The genus Cutibacterium, formerly Propionibacterium [11], constitutes aero-tolerant anaerobic gram-negative bacilli designated for the cutaneous species [11]. Cutibacterium acnes constitute an important part of the normal flora of human skin, living in and around sweat glands and sebaceous glands [12]. Under physiological conditions, C. acnes is normally a commensal bacterium on the surface of healthy skin. They anaerobically proliferate deeply within follicles and pores by metabolizing sebum triglycerides from the surrounding skin tissues and using them as a primary source of energy and nutrients [11]. The second very abundant bacteria displayed on the skin surface is gram-positive Staphylococcus epidermidis. They are facultative anaerobic microorganisms usually involved in superficial infections within the sebaceous unit [6].
Today, there are many ways how to treat acne vulgaris. Topical antibiotics and or chemical peeling agents are being used currently in acne vulgaris treatment; however, oral antibiotics, retinoids, or hormones are prescribed daily [13]. Acne pharmacotherapies are effective but are associated with adverse events such as mood disorders, antibiotic resistance and can leave the skin dry with irritation feelings [14]. Benzoyl peroxide and salicylic acid are non-antibiotic pharmaceuticals frequently administrated in a way of creams to decrease the risk of developing antibiotic resistance and to reduce inflammation [15].
The first description of antimicrobial resistance to antibiotics for C. acnes was in 1979 [16] Due to the development of resistant bacterial strains, the number of publications on the antimicrobial activity of phytochemicals is increasing [13,17]. One very promising plant-derived materials are essential oils.
Essential oils (EOs) are volatile, natural, complex compounds characterized by a strong odor and are formed by aromatic plants as secondary metabolites. They are usually obtained by steam or hydro-distillation first developed in the Middle Ages by Arabs [18]. As natural products, they possess interesting physicochemical characteristics with high added values respecting the environment. EOs also have diverse and relevant biological activities such as bactericidal, virucidal, and fungicidal, which have gained them a renewed interest in many areas [19]. Initially, they were discovered and utilized in traditional medicine and used as fragrances and food preservatives not only because of their antibacterial capabilities [20].
EOs as natural products suffer from different quality, quantity, and composition mainly due to cultivation conditions such as climate, soil composition, plant organ, age, and vegetative cycle stage [21]. To ensure the product quality and composition, the whole process must be held under conservative conditions (organ of the plant, soil, climate, and harvest season). Most of the commercialized essential oils are analyzed by gas chromatography and mass spectrometry analysis. Analytical monographs have been published (European Pharmacopeia, ISO, WHO, Council of Europe) [22].
A decrease in activity during storage can be a major drawback of many naturally active compounds. Applications of EOs in the encapsulated form to prolong their stability and to maintain biological activity are seen more often, for example in form of nanofibers for food packaging [23], in nanoemulsions, chitosan nanoparticles [20], liposomes and solid lipid nanoparticles [19] and many others.
Encapsulation technology with nanometric sizes has been remarkably developed to increase the stabilization, activity, and target delivery of bioactive components [24]. Among various nanostructure carriers, such as nanoparticles, nano-platelets, nanoplatelets, nanorods, nanowires and nanofibers, the last mentioned have the ability to create films and be used as patches, protection packaging, filters, and many others. Due to the high surface-to-volume ratio, nanofibers have unique properties such as superior mechanical strength and high porosity with different pore sizes [23,24,25,26].
Various techniques have been developed to obtain nanofibers. Among these techniques belong wet spinning, dry spinning, met pinning, self-assembly, and electrospinning and force spinning [27].
Electrospinning, as one of the simplest methods, holds many other advantages as well. Some of them are the ability to control fiber properties (e.g., diameter, porosity, and morphology) and possible scale-up [28]. The typical setup comprises a polymer that is transferred via a pump through a nozzle tip. By applying a high voltage between the nozzle and the collector, an electrical field is formed which ends in the formation of a Taylor cone, and fibers are collected over the surface of the collector [29]. Recently, some innovative electrospinning techniques were introduced, such as a simple, quick, and cost-effective strategy to manufacture nanofiber-constructed yarns combining conventional electrospinning technique with hand winding and stretching [30] or preparation of tryptophan-based poly(ester urea)s composite mats with good biodegradation and biocompatibility [31]. Another intriguing technique is solution blow spinning, in which the electrical field is replaced by the high-velocity gas flow. Since a high-voltage power source is not required, the collector could be nearly anything, from common flat collectors to living tissue such as a human hand [32].
There has been increased interest in the production of natural-based materials including nanofibers due to their bio-comparability and non-toxicity. One of the integrating food grade spin-able biopolymers is gelatin. It is the most abundant structural protein found in animal connective tissues such as skin, tendon, cartilage, and bone. Gelatin has multiple functions such as enhancing food products’ elasticity, stability, and consistency [33].
In this study, we aimed to the determination of the antimicrobial activity of two essential oils: Lavandula angustifolia and Mentha piperita. This was achieved by determination of the minimal inhibition and bactericidal concentrations (MIC and MBC) by the broth microdilution method, metabolic resazurin assay, and agar pinch method against C. acnes and S. epidermidis. Characterization of EOs was carried out by determining antioxidant activity using TEAC assay, HPLC analysis of allergens, and GC/MS analysis of chemical composition. Subsequently, essential oils were encapsulated into gelatin nanofibers to ensure proper dosage, and their antimicrobial properties were tested by agar diffusion tests as well on both bacterial strains. Moreover, a disc diffusion test of pure EOs and 20% EOs in almond oil was carried out to compare with data from agar plate tests with gelatin nanofibers. Finally, a scanning electron microscope (SEM) was utilized to photograph the nanofibers that had been created, as well as to analyze and compare fiber diameter and morphology.
2. Materials and Methods
2.1. Chemical Composition of Essential Oils
Commercial essential oils from Mentha piperita and Lavandula angustifolia were purchased from Saloos naturcosmetic (Blansko, The Czech Republic) marked in the following text and tables with the letter “S” (plant origin: peppermint India and lavender France—Provence) and Fichema Inc. (Brno, The Czech Republic) marked in the following text and tables with the letter “F” (plant origin: Peppermint from Spain, lavender from Bulgaria). Gelatin was purchased from Penta, Czech Republic. The composition, according to the manufacturers, is listed in Table 1 and Table 2.
Table 1.
Chemical composition of Lavandula angustifolia according to the manufacturer.
Table 2.
Chemical composition of Metha piperita EOs according to manufacturer.
For characterization of the chemical composition of essential oils from Mentha piperita and Lavandula angustifolia besides composition obtained by the manufacturer, antioxidant activity TEAC assay, HPLC analysis of allergens, and composition by GC/MS have been performed.
2.1.1. Antioxidant Activity
For evaluation of antioxidant activity, Trolox equivalent assay with ABTS·+ cation radical was performed [34]. ABTS radical was prepared by mixing 7 mM ABTS (2,2’–azino–bis(3–ethylbenzothiazoline–6–sulfuric acid) diammonium salt) (Sigma–Aldrich, St. Louis, MO, USA), with 2.45 mM potassium persulphate (Sigma–Aldrich, St. Louis, MO, USA) in deionized water and allowed the mixture to stand in the dark at room temperature for 12–16 h before use. Before the start of the analysis, ABTS·+ solution was diluted with UV-vis ethanol for absorption A = 0.70 ± 0.02 at 734 nm with ethanol as blank. For measurement of antioxidant activity, 1 mL of diluted ABTS·+ and 10 μL aliquot of sample was added into the Eppendorf test tube, mixed, and kept in the dark. The decrease in absorption was measured after 10 min. The calibration curve was prepared by Trolox dilution in the range of concentration 50–400 μg/mL. Values are represented as mean ± standard deviation (SD) of three replicate determinations.
2.1.2. Determination of Allergens Content by HPLC
As allergens are common compounds that can be found in essential oils, HPLC analysis with the reversed phase was performed according to [35]. Analysis was performed on HPLC/PDA Dionex UltiMate 3000 (Thermo Fischer Scientific, Waltham, MA, USA), DAD detector Vanquish series (Thermo Fischer Scientific, Waltham, MA, USA), column YMC-Triart C18 ExRS S-3 µm, 8 nm Analytical HPLC Column, 150 mm × 4.6 mm.
2.1.3. Composition Determined by GC/MS
HS-SPME-GC-MS was employed for analysis of major components on TraceTM 1310 split/splitless injector (Thermo Fisher Scientific Inc., Waltham, MA, USA) with mass detector ISQTM LT Single Quadrupole (Thermo Fisher Scientific Inc., Waltham, MA, USA). Sample extraction conditions were as follows: 10 min incubation at 40 °C, 20 min extraction at 40 °C to PDMS/CAR/PVB fiber injector temperature 240 °C, and desorption time 20 min. Analysis was performed on the capillary column TG-WaxMS, 30 m × 0.25 mm × 0.5 μm. Helium was used as carrying gas at a flow rate of 1 mL·min−1. The temperature program was set for 40 °C for 1 min and 5 °C/min until 220 °C with 12 min hold. The mass detector was in electron ionization mode and set for 70 eV, ion source temperature 200 °C, scanning range 30–400 m/z, scanning speed 0.2 s.
2.2. Antimicrobial Susceptibility Tests
Microorganisms were obtained from the Czech Collection of Microorganisms (CCM, Czech Republic) namely Cutibacterium acnes CCM 3437 and Staphylococcus epidermidis CCM 4418. Lyophilized cultures were rehydrated and cultured according to manufacturer recommendations. Both microorganisms were cultivated on BHI media (Himedia, Brno, Czech Republic) at 37 °C in (KS 4000 I control, IKA, Königswinter, Germany) for 24 h. Microorganisms were subsequently seeded into fresh media at the concentration of 0.5 McFarland units (approximately 1.5·108 cells/mL). In the case of cultivation on solid media, 20 g/L of microbiological agar (Sigma-Aldrich, St. Louis, MO, USA) was added, before the sterilization, to the media.
For the purpose of this study, preliminary broth dilution tests on a 96-well plate were carried out to determine whether selected essential oils possess good antimicrobial activity and are suitable for encapsulation into electrospinning nanofibers. The Minimal Inhibition Concentration (MIC) and Minimal Bactericidal Concentration (MBC) were determined for all EOs samples. Moreover, disc diffusion tests of pure and 20% diluted EOs in almond oil were performed. In the case of nanofibers with essential oils, diffusion tests on agar plates were performed as well. The goal was to assess whether gelatin nanofibers can be used as carriers of antimicrobial compounds of proper EOs dosages, which will not affect surrounded micro-biome and skin and to only act on the spot of application.
2.2.1. Preliminary Broth Microdilution Tests Minimal Inhibition Concentration (MIC) Assay
For the first screening, the broth dilution method was chosen and performed on a 96-well plate. Both Cutibacterium acnes (CA) and Staphylococcus epidermidis (SE) cultures were firstly cultivated in Erlenmeyer flasks and the 24 h culture was then sub-cultured by adding 100 μL of diluted cultures onto a 96-well plate. Before the analysis, each sample was diluted 5 times in ethanol for UV-vis spectrophotometry. Subsequently, a 2-fold dilution was prepared in the cultivation media to obtain the concentration range of 0.012–25 μL/mL. As positive control that possesses antimicrobial activity, ampicillin (Sigma-Aldrich, St. Louis, MO, USA) was used at starting concentration of 25 μg/mL. Prepared 96-well plates were read on a well plate reader (Synergy HTX, Agilent Technologies, Inc., Santa Clara, CA, USA) at 630 nm and placed into an incubator, and cultivated for 24 h at 37 °C. In the case of C. acnes, all wells were sealed to ensure anaerobic conditions. Afterward, the absorption was measured again at 630 nm. Antimicrobial activity was calculated as a percentage of control with non-treated microbial culture. Each sample dilution was tested in triplicates. The antimicrobial efficiency is described as MIC90 concentration at which 90% of the microbial cells were inhibited [36].
2.2.2. Resazurin Reduction Assay
The metabolic assay was performed using a resazurin reduction assay. After 24 cultivation of samples with microbial culture, 20 μL of resazurin solution (0.15 mg/mL in PBS) was added into each well. Microplates were placed back into the incubator for 30 min at 37 °C. After incubation, the plates were read at 570 nm as the conversion of resazurin to resorufin is associated with a shift in absorbance spectrum (resazurin: λmax = 600 nm, resorufin: λmax = 570 nm) [37]. Absorbance from control wells with media only was deducted from each well. Metabolic activity was calculated as a percentage of positive control (media with MO). Each sample dilution was tested in triplicates. A change from blue to pink indicates the reduction of resazurin and therefore bacterial growth. The MIC was defined as the lowest drug concentration that prevented this color change [38].
2.2.3. Minimal Bactericidal Concentration Test (MBC)
For determination of minimal bactericidal concentration samples after 24 h cultivations were transferred from 96-well plates onto BHI agar plates using a sterile inoculation needle and incubated for another 24 h at 37 °C [17]. After cultivation, bacterial colonies were observed and visualized by a camera. MBC is defined as the lowest concentration that completely inhibited bacterial growth [39]. Bactericidal concentration was evaluated as the lowest concentration at which no bacterial colony was observed after 24 h of cultivation. Each determination was performed in triplicate.
2.2.4. Agar Diffusion Tests
In the case of Staphylococcus epidermidis, 100 μL of 24 h culture was inoculated and spread on the surface of the agar plate by a cell spreader. This type of inoculation was used to assess whether the antimicrobial effect of samples is only local (on the spot of application) and does not alter the viability of surrounding bacterial cells. Essential oils were encapsulated into gelatin nanofibers and tested for antimicrobial activity by agar diffusion test [40]. After 24 h incubation at 37 °C, inhibition zones were observed and measured.
In the case of Cutibacterium acnes, the 24 h culture was inoculated with an inoculation needle on agar in several punctures to mimic the conditions where C. acnes proliferates anaerobically deep in the follicles and pores by metabolizing sebum triglycerides from the surrounding skin tissues. This type of experiment was carried out to confirm that active compounds from samples are released into the agar and act in the depth of the inflamed follicle. Gelatin nanofibers with encapsulated EOs were placed on one of the punctures to observe the local antimicrobial effect against C. acnes. After 24 h incubation at 37 °C, the growth of the bacteria in covered punctures and the possible affection of the uncovered punctures were observed.
Besides these samples, pure essential oils and 20% essential oils were diluted in almond oil (20% v/v) and 10 μL were applied on the diffusion disc and placed on a BHI agar plate with inoculated bacterial cultures. Ampicillin stock solution (25 μg/mL) was used as a positive control that possesses antimicrobial activity. 100% almond oil was used as a negative control that had no antimicrobial activity on selected bacterial strains. All samples were made in triplicates.
2.3. Preparation of Gelatin Nanofibers
For nanofiber preparation, the electrospinning technique was employed. Nanofiber films loaded with essential oils were prepared as follows: gelatin solution 30% (w/v) was prepared in 50% acetic acid [41]. Nanofibers loaded with essential oils were prepared by additions of 20% (w/w) of nanofiber material, stirred for 10 min, and placed into a syringe with a metallic needle with a diameter of 1 mm.
Nanofibers were prepared on the in-house assembled device that consisted of a high-voltage source, NE-1010 Higher Pressure Syringe Pump (KF Technology SRL Italy), and the metal collector (25 cm × 25 cm) covered with aluminum foil.
Each sample was collected on the new aluminum sheet. The positive charge was placed on the tip of the needle through the spinning solution, pushed by a syringe pump. The negative charge was placed on a collector. The electrospinning condition was set as follows: 15 cm distance of the needle from the metal collector, 15 kV, needle diameter of 1 mm, and temperature of 22 °C with humidity of approximately 40–50%. After collection, all samples were weighed and stored in plastic sample bags at laboratory temperature.
2.4. Nanofiber Characterization
In order to characterize prepared nanofibers from gelatin, scanning electron microscopy was employed. Microscope ZEISS EVO LS 10 (ZEISS, Jena, Germany) was operated under high-vacuum mode and acceleration voltages of 5 kV. The sample surfaces were sputtered for 1 min with Au. Fiber diameter was measured as well by the microscope software SmartSEM (ZEISS, Jena, Germany) tool.
2.5. Cytotoxicity Assays
For MTT cytotoxicity assays human epidermal keratinocyte cell line (HaCaT) was obtained from CLS Cell Lines Service GmbH (Eppelheim, Germany). Cells were maintained in Dulbecco’s Modified Eagle Medium (DMEM) (Lonza Biotec, Kouřim, The Czech Republic) with High Glucose, with 0.4 mM L-Glutamine, without Sodium Pyruvate, supplemented with 100 mg/mL of streptomycin, 100 units/mL of penicillin, and 10% of heat-inactivated fetal bovine serum (FBS). Cultivation was performed in humidified, 5% (v/v) CO2 atmosphere at 37 °C. Cell culture was fed every 2–3 days and passaged after reaching 80% of confluence [42].
2.6. MTT Assay
Tested samples were treated according to Li et al. as follows: samples were diluted, pipetted through a 200 nm syringe filter, and diluted with DMEM until the concentration range of 0.012–0.75 μL/mL.
Firstly, 100 μL of properly diluted cell culture was added to a 96–well plate and left in the incubator. After 24 h medium was replaced by prepared samples in DMEM and placed back into the incubator. The control was DMEM medium, and 60% ethanol served as a negative control. Subsequently, after another 24 h 20 μL of MTT dissolved in PBS (2.5 mg·mL−1) was added to each sample and incubated for 3 h in an incubator, and then 100 μL of 10% SDS in PBS was added to each well. Plates were stored in dark and evaluated the next day by ELISA Reader at 543 nm [43].
2.7. Statistical Analysis
All experiments were performed in triplicates. Results are presented as mean ± standard deviation (SD). For hypothesis testing, a one-way ANOVA was used and set at a significance level of 0.05. Data were evaluated by Tukey’s HSD test and marked as groups that had significant differences at levels 0.05; 0.001 or 0.000 1.
3. Results and Discussion
3.1. Chemical Characterization of Essential Oils
Several approaches were used for chemical characterization, including the TEAC assay for antioxidant activity, HPLC study of allergens, and GC/MS profile of compounds. The chemical composition reported by manufacturers was compared to the results of our analyses.
3.1.1. Antioxidant Activity
Antioxidant activity is together with antimicrobial activity one of the most studied biological activities for essential oils [40,44,45]. The antioxidant activity of Mentha piperita and Lavandula angustifolia is listed in Table 3.
Table 3.
Antioxidant activity of Mentha piperita and Lavandula angustifolia measured by TEAC method.
In the case of lavender samples, there was no statistical difference between their antioxidant activity. Both samples showed moderate values around 0.035 mmol TE and were in the range of 15.37 to 16.37 mg/mL for 50% scavenging concentration. Other researchers, such as Badr et al. [46], determined IC50 for lavender EO as 1 828.25 mg/L so 1.83 mg/mL. The other study of eight different lavender samples showed IC50 in the range of 61.23 to 74.08 μg/mL in ABTS scavenging assay [47]. The study of Al-Ansari et al. showed that IC50 for L. latifolia was around the value 0.3 mg/mL with ABTS+· and 0.35 mg/mL of essential oil for DPPH radical [48] and L. dentata IC50 of 14.03 ± 0.16 mg/mL in the study of Demmak et al. [49]. In the case of Lavandula genus, there was reported a similar or bigger variance in antioxidant activity by other researchers [50,51] than in the case of our samples.
In the case of mint samples, there was a significant difference between their antioxidant activity. The p-Value for these two samples was p < 0.000 1. Fichema sample originated from Spain and had SC50 of value 1.90 ± 0.02 mg/mL, while Saloos sample originated from India and exhibited 3.64 ± 0.27 mg/mL. As this value is almost double, the sample from India had half the antioxidant activity. After comparing the literature, we realized that our findings are in accordance with the study of Mollaei et al. 2020, where they compared twelve wild populations of Mentha puleguim from Azerbaijan. Their results showed that antioxidants activity ranged for IC50 between values 0.545–4.884 mg/mL [52].
3.1.2. Quantitative and Qualitative Analysis of Essential Oils
The chemical components of essential oils were defined through the analysis of allergens by HPLC and the chemical composition of GC/MS. For allergens analysis, HPLC with reversed phase was performed and the data are shown in Table 4. From 24 tested allergens, all samples contained only two of them, linalool and limonene. Lavender samples contained a high amount of linalool–441.41 mg/mL (Fichema sample from Bulgaria) and 479.05 mg/mL (Saloos sample from Provence). These results are supported by data obtained from manufacturers shown in Table 1 and Table 2 as linalool is a major component of lavender essential oil [40,53,54,55]. From other allergens, only limonene was declared by the manufacturer as well, but only in the case of lavender from Bulgaria. In this sample, 21.14 mg/mL of limonene was detected. In this sample, citral was detected as well, but it was not listed in the chemical composition of the manufacturer.
Table 4.
Quantitative and qualitative analysis of EOs.
Allergen analysis for mint samples showed that the content of allergens was not consistent. However, in the case of eugenol, both samples contained a small but similar amount of this allergen, whereas, in both lavender samples, eugenol was not detected. In other studies, eugenol was detected by GC/MS at a level of 0.02–0.3% [56,57].
Besides the data obtained from HPLC analysis of allergens, GC/MS data can provide a deeper understanding of the chemical composition of essential oils. For a comparison of the chemical composition declared by the manufacturer, we decided to perform GC/MS analysis. Measured data from GC/MS qualitative analysis are displayed in Table S1. We were able to identify 50–66 components in each sample, with only 17 of them being present in all of them. There are 65 components in Bulgarian lavender samples and 59 components in Provence lavender samples. In both lavender samples, there was a 56-component overlap. Mint samples from India contained 50 components, while mint samples from Spain contained 62 components, and both mint samples contained 40 components.
Table 1 and Table 2 demonstrate the chemical composition of lavender and mint samples as declared by manufacturers. Table 4 shows the main components presented in EOs as detected by GC/MS analysis. Eucalyptol was the main component present in all tested samples. Other components were present only in two samples, but not necessarily from the same plant. Components such as linalyl butyrate and b-caryophyllene were determined in lavender from Provence, but the same compounds were present both in mint from India and Spain.
3.2. Antimicrobial Activity Testing
The presence of volatile chemicals such as terpenes, alcohols, acids, esters, epoxides, aldehydes, ketones, amines, and sulfides terpineol, thujanol, myrcenol, neral, thujone, camphor, and carvone contribute to the essential oil’s biological activity [58]. Both broth microdilution and the agar diffusion test were used to determine antibacterial activity.
3.2.1. Preliminary Broth Dilution Tests—Minimal Inhibition Concentration (MIC) Assay
The antibacterial properties of Lavandula angustifolia and Mentha piperita EOs samples were tested against C. acnes and S.epidermidis and evaluated by determining minimum inhibitory and bactericidal concentrations (MICs and MBCs, respectively). Data are shown in Table 5.
Table 5.
MIC and MBC of lavender and mint EOs.
For lavender oil, Martucci et al. 2015 determined MIC for E. coli strain value of 2 μg/mL [54]. In the study of multiple essential oils’ antimicrobial activity against Staph. aureus strain EG-AE1, Staph. epidermidis strain EG-AE2, and Cutibacterium acnes Strain EG-AE1, they came to the conclusion that lavender essential oil does not have any antimicrobial activity in disc diffusion tests [17]. This contrasted with our findings, where MIC for both strains and both lavender samples were in the range of 6.3 to 9.4 μL/mL. As expected, minimal bactericidal concentration was higher for both lavender samples and bacterial strains and ranges from 12.5 to 25 μL/mL.
In comparison to lavender samples, both mint samples had equivalent or superior antibacterial activity. This phenomenon could be explained by the presence of a minor amount of eugenol in both mint samples, according to the chemical composition data (Table 2). Eugenol was the main ingredient in many types of essential oils produced from plants, and it had remarkable antibacterial action that had been well-studied and employed in food preservation, and the US Food and Drug Administration (FDA) has classified it as generally recognized as safe (GRAS) [33]. Another antimicrobial compound derived from Mentha piperita mint oil is carvone. This compound destabilizes the permeability of cell membranes, diminishes the ergosterol rates, and consequent reduction throughout the production of PM-ATPase [45]. MIC values against E. coli were in the range of 6.25–12.5 mg/mL and the same values were measured against S. aureus for differently treated Mentha species [59].
Based on data obtained for each bacterial strain, we can say that values of MIC and MBC are lower in the case of S. epidermidis in comparison to E. coli. This is a common phenomenon that is based on cell wall composition. In the case of gram-negative bacteria, the lipopolysaccharides outer layer permits small hydrophilic molecules and is partially permissive for hydrophobic molecules. Contrarily, Gram-positive strains such as S. epidermidis are more sensitive to essential oils based on the structure of their cell wall. Peptidoglycans in the cell wall allow the hydrophobic molecules to enter the cell [60,61]. Antibacterial agents can act in different ways. Leakage of specific cell markers, such as proteins, can indicate cytomembrane damage and integrity of cells treated by antimicrobial agents [62]. The effect of essential oils is caused predominantly by simultaneous membrane disruption that causes leakage of intracellular substances including proteins and K+ [63].
3.2.2. Discs Diffusion Test of Pure and Diluted EOs
Essential oils in pure form and diluted in almond oil at 20% (v/v) were tested against S. epidermidis and C. acnes. Inhibition zones are displayed in Table 6 and represented as the mean of three independent samples with standard deviation.
Table 6.
Antimicrobial activity of essential oils measured by disc diffusion test.
When compared to the control with almond oil, both lavender and mint samples exhibited visible inhibitory zones. There was no significant difference between the two lavender samples as well as between mint samples in pure and diluted form.
The evaluation of the diffusion test is different in the case of Staphylococcus epidermidis and Cutibacterium acnes. As mentioned above, Staphylococcus epidermidis is an opportunistic pathogen that is often found on the surface of the skin. Cutibacterium acnes is one of the most common bacteria responsible for acne manifestation and its multiplication occurs mainly in the anaerobic environment of the follicle. The purpose of this test was to find out whether the prepared nanofibrous disc is suitable for the local elimination of S. epidermidis growing mainly on the skin surface. Further, we would like to verify the release of the active substance in depth to eliminate C. acnes as well.
In Table 6, we can see that even when we diluted essential oils 5 times to 20% in almond oil, the inhibition zone diameter did not decrease 5 times but less. In the case of both Lavandula angustifolia, the reduction of inhibition zones was not 80% as expected, but only 58.9 ± 2.4%. while diluted Mentha piperita essential oils exhibited a reduction of inhibition zones by 72.3 ± 3.7%. As all samples were diluted in almond oil, pure almond oil was tested as well, and no antimicrobial zone was observed.
Antimicrobial testing against C. acnes revealed that all samples in both dilutions exhibited inhibition zones. While this testing was performed on agar plates with needle inoculation, the inhibition zones diameter was evaluated only semi-quantitatively and was displayed as the ++ sign if the inhibition zone was observed and affected both central and surrounding colonies, the + sign if the sample affected only the central colony, or the —sign when there was no visible inhibition zone (Table 6).
As the intended application of tested essential oils is as patches that will be placed only over the spot with pimples or lesions, the desired antimicrobial activity should be as well only on the spot of application. Therefore, the nanofibers patch should act locally with minimal effect on surrounding skin microbiota. For pure essential oils, both lavender samples had a local antimicrobial effect against C. acnes, while pure mint essential oils affected even surrounded colonies of C. acnes. A local effect was observed after dilution to 20% in almond oil for all samples.
There are only limited data on the antimicrobial activity of essential oils against C. acnes. In the work of Esmael et al. 2020 they tested several plant oils and from tested samples, only tea tree and rosemary oil exhibited antimicrobial activity. For the tea tree, the inhibition zone was 20.85 ± 0.76 mm and 14.77 ± 0.35 mm for rosemary oil. Very similar data were obtained in this study for antimicrobial activity against S. epidermidis [17]. Our data for S. epidermidis were very similar to data from this research in the case of Lavandula angustifolia, but even higher inhibition zones were observed in our Mentha piperita samples.
Blažeković et al. 2018 performed antimicrobial disc diffusion tests of Lavandula angustifolia samples on several gram-positive and gram-negative bacteria. For gram-positive bacterial strains, the inhibition zones for L. × intermedia ‘Budrovka’ were 15–23 ± 2 mm and 14–19 ± 1 mm, while inhibition zones for L. × intermedia ‘Budrovka’ and Lavandula angustifolia against S. aureus were 20 mm and 18 mm, respectively. In the case of gram-negative bacterial strains, the data suggest that the inhibition zones were ranging from 14 to 22 ± 2 mm for L. × intermedia ‘Budrovka’ and 12–17± 1 mm for Lavandula angustifolia [39].
Another study by Yuan et al. 2019 showed that the inhibition zones diameter for Lavandula angustifolia grown in China in disc diffusion tests was 20.22 ± 0.7 mm in the case of S. aureus and 19.86 ± 0.9 mm in the case of E. coli [40].
Despite several studies and reviews about the antimicrobial activity of Mentha components such as carvone [45] and others [64], there are only limited data on antimicrobial activity and even less against C. acnes. Zu et al. 2010 tested ten essential oils for antibacterial activity against C. acnes and they found that MIC and MBC concentrations were 0.25% (v/v) for Mentha essential oil [65].
In another study by Desam et al. 2019, inhibition zones were measured as the evidence of antimicrobial activity of Mentha piperita essential oil against several bacterial strains. Authors determined inhibition zones of 35.14 ± 0.08 mm against S. epidermidis and 27.02 ± 0.13 mm against E. coli [57].
3.2.3. Antimicrobial Activity of Gelatin Nanofibers Analyzed by Diffusion Test
After verification that selected EOs possessed antimicrobial activity, the next step was to test the antimicrobial activity of prepared nanofibers with and without EOs. The control agar plate of C. acnes after 24 h incubation and the plate with gelatin nanofibers with a 20% addition of lavender F Bulgaria EOs are presented in Table 7. The dots represent where C. acnes cells were inoculated by puncture of the agar with an inoculation needle to mimic conditions of the anaerobic proliferation of C. acnes deeply within follicles and skin pores. For gelatin nanofiber samples, the area where the sample was placed is marked. As we can see from this picture, gelatin nanofibers without any added EO had no antimicrobial effect on C. acnes. The very same we can say for gelatin fibers (Gel0) and their antimicrobial activity against S. epidermidis, as is represented in Table 7.
Table 7.
Agar diffusion tests of gelatin nanofibers with a 20% addition of EOs.
All nanofiber samples tested against C. acnes and S. epidermidis had desired local effect, whereas ampicillin affected surrounding colonies as well. Therefore, our nanofiber samples with Eos are suitable for the local treatment of acne vulgaris (plates with other tested EOs are shown in Table S2).
3.3. Morphology of Gelatin Nanofibers (Electrospun Meshes)
To observe the morphology of prepared nanofibers, scanning electron microscopy was performed within all samples. As the SEM micrograms in Table 8 are showing, the concentration of essential oils was alternated for three concentrations, namely, 0, 2, and 20% w/w of the solid material (marked as A–C and 1 for 5000 times magnification and 2 for 2000 times magnification), which had some minor effect on the sample’s morphology. The fibers exhibited a more curved shape when 20 percent essential oil is added, compared to samples with no or 2 percent essential oil, where fibers exhibit higher orientation in the X and Y axis. Fibers were spun in a higher order on the collection surface in these two samples (A and B).
Table 8.
SEM images of the morphology of electrospun gelatin fibers.
The diameter of prepared nanofibers was measured directly by the microscope software and the data from the five measurements are displayed in Table 9. In all cases, nanofibers were very uniform and had a mean diameter of approximately 430 nm.
Table 9.
Diameters of prepared fibers by electrospinning.
In Table 9 we can see the diameters of prepared nanofibers and corresponding p-Values. There was a significant difference only after the addition of 20% of essential oil into nanofibers compare to the sample with 2% of essential oil. Altogether with pictures from SEM from Table 8, we can conclude that only a 20% addition of essential oil has an impact on both fiber diameter and morphology of the prepared fibers.
3.4. MTT Cytotoxicity Assay
The HaCaT cell line is considered to be a reliable model for the assessment of different skin disorders and is frequently used in the literature to assess the biocompatibility of different EOs [66,67]. In the present study, HaCaT cells were exposed for 24 h to a concentration range of 0.012–0.75 μL/mL of tested essential oils and lethal concentrations LC10, LC50, and LC90 were extrapolated and calculated. Data are expressed as a lethal concentration in μL/mL of added samples and are shown in Table 10. Our results indicated that all samples had only a low impact on HaCaT cell line viability in the tested range of concentration (LC 10 for maximum added concentration 0.70 μL/mL). For the Mint F sample from India, it was not possible to calculate or extrapolate the LC 50 and LC 90 because, for all tested concentrations, the cell viability was around 80–90%. Therefore, the samples in the tested range could be potentially applicable to human skin.
Table 10.
Cytotoxicity effect of essential oils on HaCaT.
4. Conclusions
To summarize, the findings show that incorporating Lavandula angustifolia and Mentha piperita essential oils into gelatin nanofibers is a suitable method for producing absorbable patches for the local treatment of Acne vulgaris without causing any negative effects on the surrounding microbiome. Despite differences in the chemical composition of each sample, antioxidant activity for Lavandula angustifolia of different origins was equivalent, while for Mentha piperita, the sample from Fichema company (plant origin Spain) had two times the antioxidant activity of the sample from Saloos company (plant origin India). This research backs up previous observations that the country of the plant’s origin caused certain variations in its chemical composition and biological activity. Aside from this, antimicrobial activity data demonstrated that differences in chemical composition between samples had no significant impact on MIC and MBC and that the primary components, which were present in both samples from the same plant, were the main reason. In pure form, all samples demonstrated good antibacterial activity in agar diffusion assays. Although dilution with almond oil reduced antibacterial effectiveness, samples had an impact on bacterial growth in the surrounding area. Only after incorporation into gelatin nanofibers was the dose sufficient for the samples to act as local antibacterial agents against C. acnes and S. epidermidis, making them suitable for the local treatment of Acne vulgaris. MTT assay showed low cytotoxicity of tested samples which together with their antioxidant activity may facilitate their use in the gentle and focused treatment of different skin infections including frequently indicated Acne vulgaris.
Supplementary Materials
The following supporting information can be downloaded at https://www.mdpi.com/article/10.3390/nano13050844/s1, Table S1: Qualitative analysis obtained from GC/MS. Table S2: Agar diffusion tests of gelatin nanofibers with 20% addition of Eos.
Author Contributions
Conceptualization, R.U., D.L. and I.M.; methodology, R.U., D.L. and P.S.; validation, P.S.; formal analysis, R.U., D.L. and M.G.; investigation, D.L.; data curation, R.U., D.L. and M.G.; writing—original draft preparation, R.U.; writing—review and editing, D.L., I.M. and A.B.; visualization, R.U.; supervision, P.S. and I.M.; project administration, I.M.; All authors have read and agreed to the published version of the manuscript.
Funding
This research was funded by the Internal Grant Agency of the Brno University of Technology, grant number FCH-S-23-8330.
Data Availability Statement
Not applicable.
Acknowledgments
The authors would like to acknowledge the assistance of Ing. Monika Trudičová for imaging the nanofibers by SEM microscopy.
Conflicts of Interest
The authors declare no conflict of interest.
References
- Woo, T.E.; Sibley, C.D. The Emerging Utility of the Cutaneous Microbiome in the Treatment of Acne and Atopic Dermatitis. J. Am. Acad. Derm. 2020, 82, 222–228. [Google Scholar] [CrossRef] [PubMed]
- Chiller, K.; Selkin, B.A.; Murakawa, G.J. Skin Microflora and Bacterial Infections of the Skin. J. Investig. Dermatol. Symp. Proc. 2001, 6, 170–174. [Google Scholar] [CrossRef]
- Sarkar, S.; Patra, P.; Mridha, K.; Ghosh, S.; Mukhopadhyay, A.; Thakurta, R. Personality Disorders and Its Association with Anxiety and Depression among Patients of Severe Acne: A Cross-Sectional Study from Eastern India. Indian J. Psychiatry 2016, 58, 378–382. [Google Scholar] [CrossRef] [PubMed]
- Castellanos Lorduy, H.J.; Pérez Cely, H.C.; Casadiego Rincón, E.J.; Henao Riveros, S.C.; Colorado, C.L. Cutibacterium Acnes Tetracycline Resistance Profile in Patients with Acne Vulgaris, in a Colombian Dermatologic Center. Actas Dermo-Sifiliográficas (Engl. Ed.) 2021, 112, 873–880. [Google Scholar] [CrossRef]
- Penso, L.; Touvier, M.; Deschasaux, M.; Szabo De Edelenyi, F.; Hercberg, S.; Ezzedine, K.; Sbidian, E. Association between Adult Acne and Dietary Behaviors: Findings from the NutriNet-Santé Prospective Cohort Study. JAMA Derm. 2020, 156, 854–862. [Google Scholar] [CrossRef]
- Burkhart, C.; Burkhart, C.; Lehmann, P. Acne: A Review of Immunologic and Microbiologic Factors. Postgrad. Med. J. 1999, 75, 328. [Google Scholar] [CrossRef] [PubMed]
- Fitz-Gibbon, S.; Tomida, S.; Chiu, B.H.; Nguyen, L.; Du, C.; Liu, M.; Elashoff, D.; Erfe, M.C.; Loncaric, A.; Kim, J.; et al. Propionibacterium Acnes Strain Populations in the Human Skin Microbiome Associated with Acne. J. Investig. Dermatol. 2013, 133, 2152–2160. [Google Scholar] [CrossRef]
- Scholz, C.F.P.; Kilian, M. The Natural History of Cutaneous Propionibacteria, and Reclassification of Selected Species within the Genus Propionibacterium to the Proposed Novel Genera Acidipropionibacterium Gen. Nov., Cutibacterium Gen. Nov. and Pseudopropionibacterium Gen. Nov. Int. J. Syst. Evol. Microbiol. 2016, 66, 4422–4432. [Google Scholar] [CrossRef] [PubMed]
- Dréno, B. What Is New in the Pathophysiology of Acne, an Overview. J. Eur. Acad. Derm. Venereol. 2017, 31 (Suppl. 5), 8–12. [Google Scholar] [CrossRef]
- Dalgard, F.; Gieler, U.; Holm, J.Ø.; Bjertness, E.; Hauser, S. Self-Esteem and Body Satisfaction among Late Adolescents with Acne: Results from a Population Survey. J. Am. Acad. Derm. 2008, 59, 746–751. [Google Scholar] [CrossRef] [PubMed]
- Dréno, B.; Pécastaings, S.; Corvec, S.; Veraldi, S.; Khammari, A.; Roques, C. Cutibacterium Acnes (Propionibacterium acnes) and Acne Vulgaris: A Brief Look at the Latest Updates. J. Eur. Acad. Dermatol. Venereol. 2018, 32, 5–14. [Google Scholar] [CrossRef] [PubMed]
- Aubin, G.G.; Portillo, M.E.; Trampuz, A.; Corvec, S. Propionibacterium Acnes, an Emerging Pathogen: From Acne to Implant-Infections, from Phylotype to Resistance. Med. Mal. Infect. 2014, 44, 241–250. [Google Scholar] [CrossRef]
- Pineau, R.M.; Hanson, S.E.; Lyles, J.T.; Quave, C.L. Growth Inhibitory Activity of Callicarpa Americana Leaf Extracts against Cutibacterium acnes. Front. Pharm. 2019, 10, 1206. [Google Scholar] [CrossRef]
- Eichenfield, L.F.; del Rosso, J.Q.; Mancini, A.J.; Cook-Bolden, F.; Gold, L.S.; Desai, S.; Weiss, J.; Pariser, D.; Zeichner, J.; Bhatia, N.; et al. Evolving Perspectives on the Etiology and Pathogenesis of Acne Vulgaris. J. Drugs Derm. 2015, 14, 263–272. [Google Scholar]
- Thiboutot, D.; Gollnick, H.; Bettoli, V.; Dréno, B.; Kang, S.; Leyden, J.J.; Shalita, A.R.; Lozada, V.T.; Berson, D.; Finlay, A.; et al. New Insights into the Management of Acne: An Update from the Global Alliance to Improve Outcomes in Acne Group. J. Am. Acad. Derm. 2009, 60, S1–S50. [Google Scholar] [CrossRef]
- Sardana, K.; Gupta, T.; Garg, V.K.; Ghunawat, S. Antibiotic Resistance to Propionobacterium acnes: Worldwide Scenario, Diagnosis and Management. Expert Rev. Anti-Infect. Ther. 2015, 13, 883–896. [Google Scholar] [CrossRef]
- Esmael, A.; Hassan, M.G.; Amer, M.M.; Abdelrahman, S.; Hamed, A.M.; Abd-raboh, H.A.; Foda, M.F. Antimicrobial Activity of Certain Natural-Based Plant Oils against the Antibiotic-Resistant Acne Bacteria. Saudi J. Biol. Sci. 2020, 27, 448–455. [Google Scholar] [CrossRef] [PubMed]
- Bakkali, F.; Averbeck, S.; Averbeck, D.; Idaomar, M. Biological Effects of Essential Oils—A Review. Food Chem. Toxicol. 2008, 46, 446–475. [Google Scholar] [CrossRef]
- El Asbahani, A.; Miladi, K.; Badri, W.; Sala, M.; Addi, E.H.A.; Casabianca, H.; El Mousadik, A.; Hartmann, D.; Jilale, A.; Renaud, F.N.R.; et al. Essential Oils: From Extraction to Encapsulation. Int. J. Pharm. 2015, 483, 220–243. [Google Scholar] [CrossRef]
- Cossetin, L.F.; Garlet, Q.I.; Velho, M.C.; Gündel, S.; Ourique, A.F.; Heinzmann, B.M.; Monteiro, S.G. Development of Nanoemulsions Containing Lavandula dentata or Myristica fragrans Essential Oils: Influence of Temperature and Storage Period on Physical-Chemical Properties and Chemical Stability. Ind. Crops Prod. 2021, 160, 113115. [Google Scholar] [CrossRef]
- Angioni, A.; Barra, A.; Coroneo, V.; Dessi, S.; Cabras, P. Chemical Composition, Seasonal Variability, and Antifungal Activity of Lavandula stoechas L. Ssp. Stoechas Essential Oils from Stem/Leaves and Flowers. J. Agric. Food Chem. 2006, 54, 4364–4370. [Google Scholar] [CrossRef]
- Smith, R.L.; Cohen, S.M.; Doull, J.; Feron, V.J.; Goodman, J.I.; Marnett, L.J.; Portoghese, P.S.; Waddell, W.J.; Wagner, B.M.; Hall, R.L.; et al. A Procedure for the Safety Evaluation of Natural Flavor Complexes Used as Ingredients in Food: Essential Oils. Food Chem. Toxicol. 2005, 43, 345–363. [Google Scholar] [CrossRef] [PubMed]
- Rather, A.H.; Wani, T.U.; Khan, R.S.; Pant, B.; Park, M.; Sheikh, F.A. Prospects of Polymeric Nanofibers Loaded with Essential Oils for Biomedical and Food-Packaging Applications. Int. J. Mol. Sci. 2021, 22, 4017. [Google Scholar] [CrossRef]
- Lin, L.; Gu, Y.; Cui, H. Moringa Oil/Chitosan Nanoparticles Embedded Gelatin Nanofibers for Food Packaging against Listeria monocytogenes and Staphylococcus aureus on Cheese. Food Packag. Shelf. Life 2019, 19, 86–93. [Google Scholar] [CrossRef]
- Hadipour-Goudarzi, E.; Montazer, M.; Latifi, M.; Aghaji, A.A.G. Electrospinning of Chitosan/Sericin/PVA Nanofibers Incorporated with in Situ Synthesis of Nano Silver. Carbohydr. Polym. 2014, 113, 231–239. [Google Scholar] [CrossRef] [PubMed]
- Meziani, J.; Li, Z.; Harish, V.; Tewari, D.; Gaur, M.; Yadav, A.B.; Swaroop, S.; Bechelany, M.; Barhoum, A. Review on Nanoparticles and Nanostructured Materials: Bioimaging, Biosensing, Drug Delivery, Tissue Engineering, Antimicrobial, and Agro-Food Applications. Nanomaterials 2022, 12, 457. [Google Scholar] [CrossRef]
- Tsai, R.Y.; Hung, S.C.; Lai, J.Y.; Wang, D.M.; Hsieh, H.J. Electrospun Chitosan–Gelatin–Polyvinyl Alcohol Hybrid Nanofibrous Mats: Production and Characterization. J. Taiwan Inst. Chem. Eng. 2014, 45, 1975–1981. [Google Scholar] [CrossRef]
- Bhattarai, R.S.; Bachu, R.D.; Boddu, S.H.S.; Bhaduri, S. Biomedical Applications of Electrospun Nanofibers: Drug and Nanoparticle Delivery. Pharmaceutics 2018, 11, 5. [Google Scholar] [CrossRef]
- Ebrahimi, S.; Fathi, M.; Kadivar, M. Production and Characterization of Chitosan-Gelatin Nanofibers by Nozzle-Less Electrospinning and Their Application to Enhance Edible Film’s Properties. Food Packag. Shelf. Life 2019, 22, 100387. [Google Scholar] [CrossRef]
- Qi, Y.; Wang, C.; Wang, Q.; Zhou, F.; Li, T.; Wang, B.; Su, W.; Shang, D.; Wu, S. A Simple, Quick, and Cost-Effective Strategy to Fabricate Polycaprolactone/Silk Fibroin Nanofiber Yarns for Biotextile-Based Tissue Scaffold Application. Eur. Polym. J. 2023, 186, 111863. [Google Scholar] [CrossRef]
- Li, M.; Qiu, W.; Wang, Q.; Li, N.; Liu, L.; Wang, X.; Yu, J.; Li, X.; Li, F.; Wu, D. Nitric Oxide-Releasing Tryptophan-Based Poly(Ester Urea)s Electrospun Composite Nanofiber Mats with Antibacterial and Antibiofilm Activities for Infected Wound Healing. ACS Appl. Mater. Interfaces 2022, 14, 15911–15926. [Google Scholar] [CrossRef] [PubMed]
- Medeiros, E.S.; Glenn, G.M.; Klamczynski, A.P.; Orts, W.J.; Mattoso, L.H.C. Solution Blow Spinning: A New Method to Produce Micro- and Nanofibers from Polymer Solutions. J. Appl. Polym. Sci. 2009, 113, 2322–2330. [Google Scholar] [CrossRef]
- Li, M.; Yu, H.; Xie, Y.; Guo, Y.; Cheng, Y.; Qian, H.; Yao, W. Fabrication of Eugenol Loaded Gelatin Nanofibers by Electrospinning Technique as Active Packaging Material. LWT 2021, 139, 110800. [Google Scholar] [CrossRef]
- Re, R.; Pellegrini, N.; Proteggente, A.; Pannala, A.; Yang, M.; Rice-Evans, C. Antioxidant Activity Applying an Improved ABTS Radical Cation Decolorization Assay. Free Radic. Biol. Med. 1999, 26, 1231–1237. [Google Scholar] [CrossRef]
- Villa, C.; Gambaro, R.; Mariani, E.; Dorato, S. High-Performance Liquid Chromatographic Method for the Simultaneous Determination of 24 Fragrance Allergens to Study Scented Products. J. Pharm. Biomed. Anal. 2007, 44, 755–762. [Google Scholar] [CrossRef] [PubMed]
- Murray, C.K.; Hospenthal, D.R. Broth Microdilution Susceptibility Testing for Leptospira Spp. Antimicrob. Agents Chemother. 2004, 48, 1548. [Google Scholar] [CrossRef]
- Lavogina, D.; Lust, H.; Tahk, M.J.; Laasfeld, T.; Vellama, H.; Nasirova, N.; Vardja, M.; Eskla, K.L.; Salumets, A.; Rinken, A.; et al. Revisiting the Resazurin-Based Sensing of Cellular Viability: Widening the Application Horizon. Biosensors 2022, 12, 196. [Google Scholar] [CrossRef]
- Palomino, J.C.; Martin, A.; Camacho, M.; Guerra, H.; Swings, J.; Portaels, F. Resazurin Microtiter Assay Plate: Simple and Inexpensive Method for Detection of Drug Resistance in Mycobacterium tuberculosis. Antimicrob Agents Chemother 2002, 46, 2720. [Google Scholar] [CrossRef]
- Blažeković, B.; Yang, W.; Wang, Y.; Li, C.; Kindl, M.; Pepeljnjak, S.; Vladimir-Knežević, S. Chemical Composition, Antimicrobial and Antioxidant Activities of Essential Oils of Lavandula × intermedia ‘Budrovka’ and L. Angustifolia Cultivated in Croatia. Ind. Crops Prod. 2018, 123, 173–182. [Google Scholar] [CrossRef]
- Yuan, C.; Wang, Y.; Liu, Y.; Cui, B. Physicochemical Characterization and Antibacterial Activity Assessment of Lavender Essential Oil Encapsulated in Hydroxypropyl-Beta-Cyclodextrin. Ind. Crops Prod. 2019, 130, 104–110. [Google Scholar] [CrossRef]
- Wang, P.; Li, Y.; Zhang, C.; Feng, F.; Zhang, H. Sequential Electrospinning of Multilayer Ethylcellulose/Gelatin/Ethylcellulose Nanofibrous Film for Sustained Release of Curcumin. Food Chem. 2020, 308, 125599. [Google Scholar] [CrossRef] [PubMed]
- Bokrova, J.; Marova, I.; Matouskova, P.; Pavelkova, R. Fabrication of Novel PHB-Liposome Nanoparticles and Study of Their Toxicity in Vitro. J. Nanoparticle Res. 2019, 21, 1–12. [Google Scholar] [CrossRef]
- Li, X.; Turánek, J.; Knötigová, P.; Kudláčková, H.; Mašek, J.; Parkin, S.; Rankin, S.E.; Knutson, B.L.; Lehmler, H.J. Hydrophobic Tail Length, Degree of Fluorination and Headgroup Stereochemistry Are Determinants of the Biocompatibility of (Fluorinated) Carbohydrate Surfactants. Colloids Surf. Biointerfaces 2009, 73, 65–74. [Google Scholar] [CrossRef] [PubMed]
- Gülçin, Ì.; Şat, I.G.; Beydemir, Ş.; Elmastaş, M.; Küfrevioǧlu, Ö.I. Comparison of Antioxidant Activity of Clove (Eugenia caryophylata Thunb) Buds and Lavender (Lavandula stoechas L.). Food Chem. 2004, 87, 393–400. [Google Scholar] [CrossRef]
- Hou, T.; Sana, S.S.; Li, H.; Xing, Y.; Nanda, A.; Netala, V.R.; Zhang, Z. Essential Oils and Its Antibacterial, Antifungal and Anti-Oxidant Activity Applications: A Review. Food Biosci. 2022, 101716. [Google Scholar] [CrossRef]
- Badr, M.M.; Badawy, M.E.I.; Taktak, N.E.M. Characterization, Antimicrobial Activity, and Antioxidant Activity of the Nanoemulsions of Lavandula spica Essential Oil and Its Main Monoterpenes. J. Drug Deliv. Sci. Technol. 2021, 65, 102732. [Google Scholar] [CrossRef]
- Kıvrak, Ş. Essential Oil Composition and Antioxidant Activities of Eight Cultivars of Lavender and Lavandin from Western Anatolia. Ind. Crops Prod. 2018, 117, 88–96. [Google Scholar] [CrossRef]
- Al-Ansari, M.M.; Andeejani, A.M.I.; Alnahmi, E.; AlMalki, R.H.; Masood, A.; Vijayaraghavan, P.; Rahman, A.A.; Choi, K.C. Insecticidal, Antimicrobial and Antioxidant Activities of Essential Oil from Lavandula latifolia L. and Its Deterrent Effects on Euphoria leucographa. Ind. Crops Prod. 2021, 170, 113740. [Google Scholar] [CrossRef]
- Dammak, I.; Hamdi, Z.; Kammoun El Euch, S.; Zemni, H.; Mliki, A.; Hassouna, M.; Lasram, S. Evaluation of Antifungal and Anti-Ochratoxigenic Activities of Salvia Officinalis, Lavandula Dentata and Laurus Nobilis Essential Oils and a Major Monoterpene Constituent 1,8-Cineole against Aspergillus carbonarius. Ind. Crops Prod. 2019, 128, 85–93. [Google Scholar] [CrossRef]
- El Hamdaoui, A.; Msanda, F.; Boubaker, H.; Leach, D.; Bombarda, I.; Vanloot, P.; El Aouad, N.; Abbad, A.; Boudyach, E.H.; Achemchem, F.; et al. Essential Oil Composition, Antioxidant and Antibacterial Activities of Wild and Cultivated Lavandula mairei Humbert. Biochem. Syst. Ecol. 2018, 76, 1–7. [Google Scholar] [CrossRef]
- Cherrat, L.; Espina, L.; Bakkali, M.; Pagán, R.; Laglaoui, A. Chemical Composition, Antioxidant and Antimicrobial Properties of Mentha pulegium, Lavandula stoechas and Satureja calamintha Scheele Essential Oils and an Evaluation of Their Bactericidal Effect in Combined Processes. Innov. Food Sci. Emerg. Technol. 2014, 22, 221–229. [Google Scholar] [CrossRef]
- Mollaei, S.; Ebadi, M.; Hazrati, S.; Habibi, B.; Gholami, F.; Sourestani, M.M. Essential Oil Variation and Antioxidant Capacity of Mentha pulegium Populations and Their Relation to Ecological Factors. Biochem. Syst. Ecol. 2020, 91, 104084. [Google Scholar] [CrossRef]
- Marincaş, O.; Feher, I. A New Cost-Effective Approach for Lavender Essential Oils Quality Assessment. Ind. Crops Prod. 2018, 125, 241–247. [Google Scholar] [CrossRef]
- Martucci, J.F.; Gende, L.B.; Neira, L.M.; Ruseckaite, R.A. Oregano and Lavender Essential Oils as Antioxidant and Antimicrobial Additives of Biogenic Gelatin Films. Ind. Crops Prod. 2015, 71, 205–213. [Google Scholar] [CrossRef]
- Virgiliou, C.; Zisi, C.; Kontogiannopoulos, K.N.; Nakas, A.; Iakovakis, A.; Varsamis, V.; Gika, H.G.; Assimopoulou, A.N. Headspace Gas Chromatography-Mass Spectrometry in the Analysis of Lavender’s Essential Oil: Optimization by Response Surface Methodology. J. Chromatogr. 2021, 1179, 122852. [Google Scholar] [CrossRef] [PubMed]
- Ilić, Z.S.; Milenković, L.; Tmušić, N.; Stanojević, L.; Stanojević, J.; Cvetković, D. Essential Oils Content, Composition and Antioxidant Activity of Lemon Balm, Mint and Sweet Basil from Serbia. LWT 2022, 153, 112210. [Google Scholar] [CrossRef]
- Desam, N.R.; Al-Rajab, A.J.; Sharma, M.; Mylabathula, M.M.; Gowkanapalli, R.R.; Albratty, M. Chemical Constituents, in Vitro Antibacterial and Antifungal Activity of Mentha × piperita L. (Peppermint) Essential Oils. J. King Saud. Univ. Sci. 2019, 31, 528–533. [Google Scholar] [CrossRef]
- Calo, J.R.; Crandall, P.G.; O’Bryan, C.A.; Ricke, S.C. Essential Oils as Antimicrobials in Food Systems—A Review. Food Control 2015, 54, 111–119. [Google Scholar] [CrossRef]
- Chrysargyris, A.; Xylia, P.; Botsaris, G.; Tzortzakis, N. Antioxidant and Antibacterial Activities, Mineral and Essential Oil Composition of Spearmint (Mentha spicata L.) Affected by the Potassium Levels. Ind. Crops Prod. 2017, 103, 202–212. [Google Scholar] [CrossRef]
- Jamróz, E.; Juszczak, L.; Kucharek, M. Investigation of the Physical Properties, Antioxidant and Antimicrobial Activity of Ternary Potato Starch-Furcellaran-Gelatin Films Incorporated with Lavender Essential Oil. Int. J. Biol. Macromol. 2018, 114, 1094–1101. [Google Scholar] [CrossRef]
- Man, A.; Santacroce, L.; Jacob, R.; Mare, A.; Man, L. Antimicrobial Activity of Six Essential Oils Against a Group of Human Pathogens: A Comparative Study. Pathogens 2019, 8, 15. [Google Scholar] [CrossRef] [PubMed]
- Bajpai, V.K.; Sharma, A.; Baek, K.H. Antibacterial Mode of Action of Cudrania tricuspidata Fruit Essential Oil, Affecting Membrane Permeability and Surface Characteristics of Food-Borne Pathogens. Food Control 2013, 32, 582–590. [Google Scholar] [CrossRef]
- Xiang, F.; Bai, J.; Tan, X.; Chen, T.; Yang, W.; He, F. Antimicrobial Activities and Mechanism of the Essential Oil from Artemisia argyi Levl. et Van. Var. Argyi Cv. Qiai. Ind. Crops Prod. 2018, 125, 582–587. [Google Scholar] [CrossRef]
- Maddheshiya, S.; Ahmad, A.; Ahmad, W.; Zakir, F.; Aggarwal, G. Essential Oils for the Treatment of Skin Anomalies: Scope and Potential. S. Afr. J. Bot. 2022, 151, 187–197. [Google Scholar] [CrossRef]
- Zu, Y.; Yu, H.; Liang, L.; Fu, Y.; Efferth, T.; Liu, X.; Wu, N. Activities of Ten Essential Oils towards Propionibacterium acnes and PC-3, A-549 and MCF-7 Cancer Cells. Molecules 2010, 15, 3200–3210. [Google Scholar] [CrossRef]
- Kozics, K.; Bučková, M.; Puškárová, A.; Kalászová, V.; Cabicarová, T.; Pangallo, D. The Effect of Ten Essential Oils on Several Cutaneous Drug-Resistant Microorganisms and Their Cyto/Genotoxic and Antioxidant Properties. Molecules 2019, 24, 4570. [Google Scholar] [CrossRef]
- Alexa, V.T.; Galuscan, A.; Soica, C.M.; Cozma, A.; Coricovac, D.; Borcan, F.; Popescu, I.; Mioc, A.; Szuhanek, C.; Dehelean, C.A.; et al. In Vitro Assessment of the Cytotoxic and Antiproliferative Profile of Natural Preparations Containing Bergamot, Orange and Clove Essential Oils. Molecules 2022, 27, 990. [Google Scholar] [CrossRef]
Disclaimer/Publisher’s Note: The statements, opinions and data contained in all publications are solely those of the individual author(s) and contributor(s) and not of MDPI and/or the editor(s). MDPI and/or the editor(s) disclaim responsibility for any injury to people or property resulting from any ideas, methods, instructions or products referred to in the content. |
© 2023 by the authors. Licensee MDPI, Basel, Switzerland. This article is an open access article distributed under the terms and conditions of the Creative Commons Attribution (CC BY) license (https://creativecommons.org/licenses/by/4.0/).